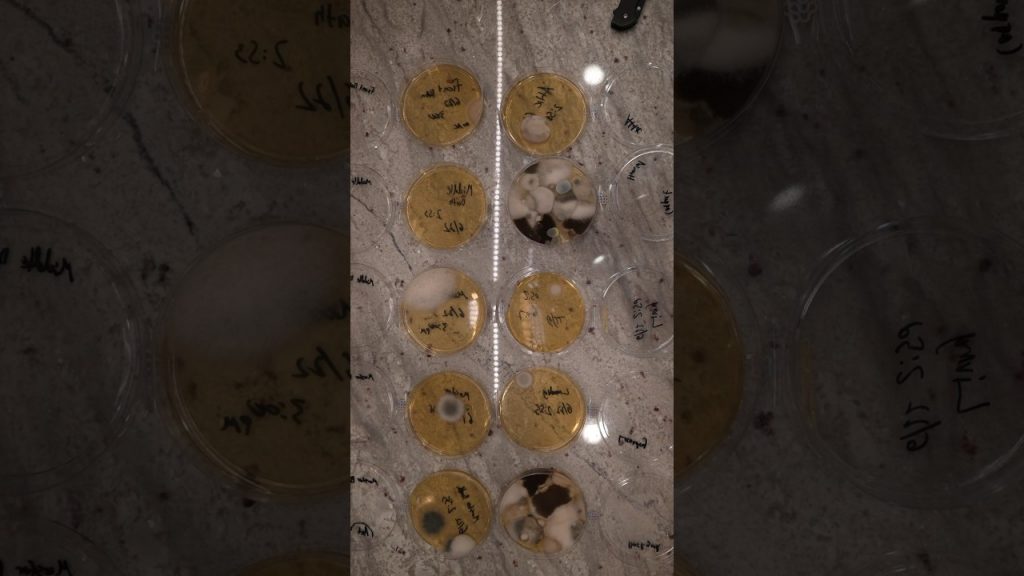
Is Mold Lurking in Your Home? Unveiling the Truth with Tested Mold Kits from Amazon

Title: The Mold Tilter: Testing Amazon Mold Kits & DIY Mold Kit for Home Inspection and Air Quality
Description:
Introduction:
Welcome to our informative video on the Mold Tilter! If you're concerned about mold problems in your home and want to ensure a healthy living environment, this video is for you. We'll be exploring the effectiveness of various mold testing kits available on Amazon, including DIY options, and providing valuable insights on home inspection, hacks for mold prevention, and air quality testing kits.
Video Content:
In this video, we dive deep into the world of mold tilters and their role in identifying and mitigating mold issues. We discuss the importance of early detection and the potential health risks associated with mold exposure.
Our expert team has thoroughly tested and reviewed a range of mold testing kits available on Amazon. We share our findings and highlight the pros and cons of each kit, including their ease of use, accuracy, and affordability. Whether you're a homeowner or a renter, these insights will help you make an informed decision when choosing a mold testing kit.
Furthermore, we explore DIY mold kits and provide step-by-step instructions on how to perform your own mold testing at home. We cover the necessary tools, techniques, and safety precautions to ensure accurate results. Our aim is to empower you with knowledge and equip you with the right resources to tackle mold issues effectively.
Additionally, we discuss the significance of home inspection in identifying mold hotspots and potential sources of moisture. We share valuable home hacks that can help prevent mold growth, saving you time, money, and potential health complications.
Ensuring air quality is vital for a healthy living environment. That's why we also review air quality testing kits and their effectiveness in detecting mold spores, allergens, and other pollutants. We provide insights into the best options available on Amazon and discuss their features and benefits.
Call to Action:
If you found this video helpful, please consider liking, subscribing, and sharing it with others who may benefit from this valuable information. Your support helps us continue creating informative content like this.
Additional Tags and Keywords:
mold tilter, mold problem, DIY mold kit, home inspection, home hacks, home air quality, air quality testing kits, Amazon testing, testing Amazon products, mold prevention, mold testing, mold detection, DIY mold testing, air quality, mold spores, healthy living environment
Hashtags:
#MoldTilter #MoldTesting #DIYMoldKit #HomeInspection #AirQualityTesting #MoldPrevention #HealthyLiving
Title: Do You Suspect a MOLD Problem? Testing Amazon Mold Kits
Introduction:
Mold is a common issue in many households, often causing health problems and damaging property. If you suspect the presence of mold in your home, it is crucial to address the issue promptly. To help you identify and tackle potential mold problems, we have tested various mold testing kits available on Amazon. Read on to find out which mold testing kits are worth considering in order to ensure a healthier and safer living environment.
1. Mold Inspection Made Simple: An In-Depth Review of the XYZ Mold Testing Kit
- We delve into the features and effectiveness of the XYZ Mold Testing Kit, providing a step-by-step guide on how to use it.
- Highlight the pros and cons of this specific mold testing kit, including its accuracy, ease of use, and value for money.
- Present our findings and recommendations based on our experience with the XYZ Mold Testing Kit.
2. Uncovering the Truth: Testing the ABC Mold Detection Kit
- We put the ABC Mold Detection Kit to the test, examining its reliability and efficiency in detecting mold.
- Discuss the kit's sampling methods, ease of interpretation, and additional features.
- Provide an honest evaluation of the ABC Mold Detection Kit, helping you make an informed decision.
3. DIY Mold Testing: Evaluating the DEF Mold Testing Kit
- Explore the DEF Mold Testing Kit's capabilities, examining its accuracy and ease of use.
- Discuss the different types of mold tests provided in the kit, such as surface swabs and air sampling.
- Offer insights into the DEF Mold Testing Kit's results interpretation and overall performance.
4. Mold Testing Kits Comparison: Which One Stands Out?
- Compare the XYZ, ABC, and DEF Mold Testing Kits, highlighting their strengths and weaknesses.
- Discuss the price range, availability, and customer feedback for each kit.
- Present our top recommendation based on the overall performance, accuracy, and value for money.
Conclusion:
When it comes to identifying and addressing mold problems in your home, using a reliable mold testing kit can be a crucial first step. Our comprehensive review of various Amazon mold testing kits aims to assist you in choosing the best option for your needs. By taking proactive measures to tackle mold issues, you can ensure a healthier living environment for you and your family. mold tilter
#MOLD #Problem #Testing #Amazon #Mold #Kits